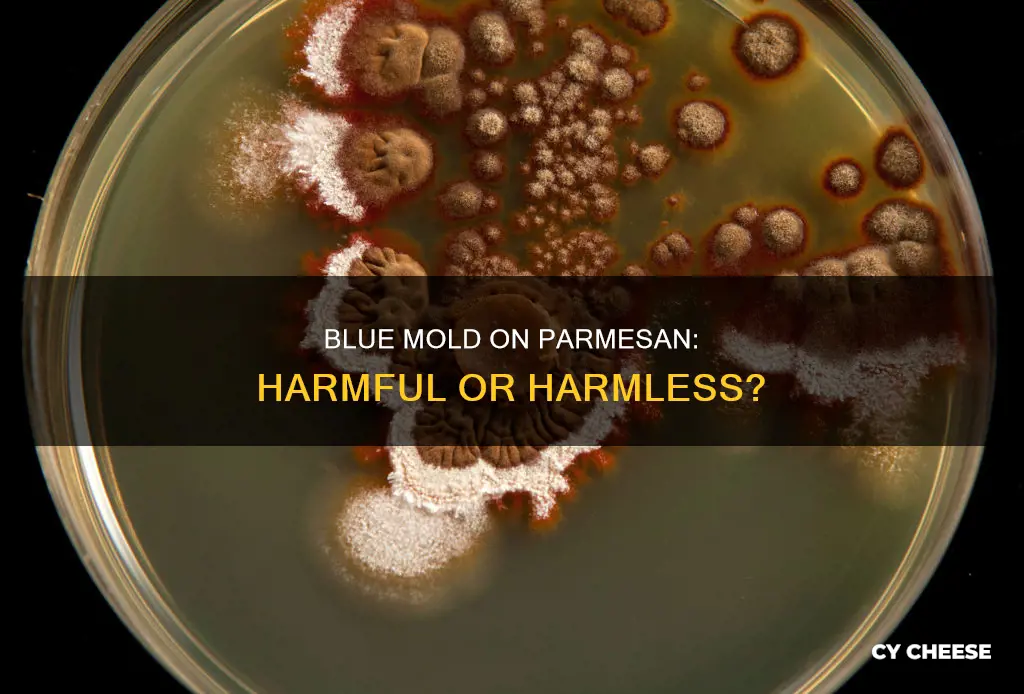
is blue mold on parmesan cheese harmful

It's a common misconception that all mould on food is harmful. While it's true that mould on some foods, such as peanuts, is toxic, mould on other foods, such as peanuts or bread, is not harmful. In the case of Parmesan cheese, the mould is typically not harmful, as it is a hard and salty cheese, which makes it difficult for mould roots to penetrate the surface. However, it's important to use your discretion, as consuming large amounts of mould or mouldy cheese that has been contaminated by bacteria could potentially cause health issues.
| Characteristics | Values |
|---|---|
| Is blue mold on parmesan cheese harmful? | Ingesting mold on food is generally not toxic, except in the case of peanuts. |
| What to do if there is mold on parmesan cheese? | It is recommended to cut off the moldy part and consume the rest of the cheese. |
| How to prevent mold on parmesan cheese? | Keep the cheese in a dry environment as microorganisms thrive in wet environments and are less active in dry ones. |
Explore related products
What You'll Learn

Blue mold on Parmesan is non-toxic
It is generally advised to throw away mouldy food, including cheese. However, ingesting mould on food is usually not toxic, and cooking the mouldy food can further reduce the risk of harm.
Parmesan cheese is a hard, salty cheese, and microorganisms that cause mould are less active in such environments. This means that mould will likely only affect the surface level of the cheese and will not penetrate the interior.
Furthermore, blue mould on Parmesan cheese is non-toxic. While it is always recommended to cut off mouldy parts of Parmesan cheese, ingesting small amounts of blue mould will likely not be harmful. This is because blue mould on Parmesan is similar to the mould on blue cheese, which is safe to eat.
However, mouldy food can negatively impact flavour and texture. Therefore, it is best to avoid eating mouldy cheese whenever possible. If there is an excessive amount of mould on the cheese, it is best to discard it. Additionally, if there are signs of other contaminants, such as bacteria, the cheese may cause illness and should be thrown away.
Blue Cheese: A Real Cheese or Not?
You may want to see also

Parmesan is a hard, salty cheese, so mold roots won't penetrate it deeply
It is generally advised to throw away mouldy food, including cheese. However, some types of cheese are made with mould and are safe to eat, such as blue cheese, Brie, and Camembert. Parmesan is a hard, salty cheese, so mould roots won't penetrate it deeply. While mould on Parmesan cheese is not likely to be harmful, it's still recommended to cut off a large margin around the mould to ensure that all traces of it are removed.
Mould thrives in wet environments and is less active in dry ones. This means that mould roots will struggle to penetrate the surface of hard, salty cheeses like Parmesan. On the other hand, mould can more easily penetrate semi-soft cheeses like Havarti or mild Cheddar, and it can quickly spread through extremely wet, fresh cheeses like mozzarella, ricotta, cream cheese, or chèvre.
While mould on Parmesan cheese is not likely to be dangerous, it's important to exercise caution. If there are only a few specks of mould on the cheese, it may be safe to consume the cheese after cutting off a substantial portion around the mould. However, if the mould is extensive, it's best to discard the entire cheese. Additionally, it's crucial to consider the health and immunity of the individuals consuming the cheese. Those with weakened immune systems may be more susceptible to adverse effects from consuming mouldy cheese.
It's worth noting that mould can negatively impact the flavour and texture of the cheese it grows on. Even if the mould itself is not harmful, it can alter the taste and make the cheese less appetizing. Therefore, it's always recommended to inspect cheese for mould and exercise discretion before consuming it.
In summary, while mould on Parmesan cheese may not pose a significant health risk, it's important to remove a generous portion around the mould and assess the extent of mould growth before consumption. It's also crucial to consider the overall health of the individuals consuming the cheese and their potential sensitivity to mould.
Blue Cheese: Is It Really Rank and Blue?
You may want to see also

Moldy Parmesan may cause an upset stomach
It is not uncommon to encounter mold on food, especially cheese. While some types of cheese are made with mold and are safe to eat, other types of moldy cheese can cause an upset stomach. Parmesan cheese, for example, can develop mold that may lead to an upset stomach.
Parmesan cheese is a hard, salty cheese with a low moisture content. This makes it less susceptible to mold growth compared to softer, more moist cheeses. However, even Parmesan cheese can eventually develop mold, especially if it is shredded or grated, increasing its surface area and exposure to the environment.
While mold on Parmesan cheese is typically not toxic, it can still cause digestive issues. In particular, individuals with weakened immune systems or young children may be more susceptible to adverse effects from consuming moldy cheese.
If you notice mold on your Parmesan cheese, it is recommended to discard it entirely. While it may be tempting to cut off the visible mold and continue consuming the cheese, there is a risk of underlying bacterial growth that may not be visible to the naked eye. Furthermore, the mold may have already affected the flavor and texture of the cheese, making it less palatable.
To prevent mold growth on Parmesan cheese, proper storage is essential. Store the cheese in an airtight container in the refrigerator, and ensure that it is consumed within a reasonable timeframe. Additionally, purchasing Parmesan cheese in smaller quantities can help reduce the risk of mold growth before consumption.
Blue Cheese Dressing: Healthy or Unhealthy Salad Topping?
You may want to see also
Explore related products

Moldy cheese should be discarded
It is generally advised to discard moldy cheese. While it may be tempting to cut off the moldy parts and consume the rest of the cheese, this may not always be safe. This is because the mold roots can penetrate the cheese, and while they are less likely to penetrate the surface of hard, salty cheeses like Parmesan, they can still grow and negatively impact the flavor and texture of the cheese.
When it comes to Parmesan cheese, it is important to note that it is a hard and salty cheese, which makes it less susceptible to mold growth. However, if mold is present, it is best to discard the cheese. This is because, while the mold itself may not be toxic, it can still affect the taste and texture of the cheese. Additionally, there is a risk of bacterial growth, especially if the cheese is wet or moist.
In the case of soft cheeses, it is even more important to discard moldy cheese. Soft cheeses are much more porous than firmer cheese and therefore can harbor the spreading of mold. This can include cheeses such as cottage cheese, cream cheese, ricotta, mozzarella, Havarti, and mild cheddar. Even if the mold is only visible on a small portion of the cheese, it is best to discard the entire product to avoid any potential health risks.
Furthermore, consuming moldy cheese can potentially cause health issues, especially for individuals with weakened immune systems. While it may not be toxic, it can still cause stomach upset and other digestive problems. Therefore, it is always recommended to err on the side of caution and discard any cheese that shows signs of mold growth.
In summary, while it may be tempting to salvage moldy cheese by cutting off the affected parts, it is generally advisable to discard it altogether. This is especially important for soft cheeses, where mold can spread more easily, and for individuals with compromised immune systems. By discarding moldy cheese, you can help ensure the safety and quality of the food you consume.
Blue Cheese and Penicillin: A Moldy Connection
You may want to see also

Some cheeses are made from edible mold
It is generally agreed that ingesting mould on food is not harmful to health, except in the case of mould on peanuts, which is toxic to the liver. Mould on Parmesan cheese is not toxic and should not be a problem if consumed. However, it is advised to cut about an inch around and below the mould spot to be sure. This is especially true if you are working with a harder cheese.
Mould is an integral part of the cheesemaking process and some cheeses are made from edible mould. For example, the thick white rind on the outside of a wheel of Brie is a type of edible mould called Penicillium candidum. This mould is what gives Brie and other "bloomy rind" cheeses their distinctive savoury, mushroom-like flavour. In fact, the job of a cheesemaker often involves mould maintenance—ensuring that the right type of mould is growing in the right place at the right time and intervening when necessary.
Blue Cheese: Spoiled or Speciality?
You may want to see also
Frequently asked questions
Blue mold on parmesan cheese is generally not harmful and is even edible. However, it is recommended to cut off the moldy part before consuming the cheese.
Mold can grow on parmesan cheese due to moisture or improper storage. It is important to store parmesan cheese in a cool, dry place to prevent mold growth.
Ingesting small amounts of mold on cheese is usually not harmful and may cause minor stomach upset. However, if you experience any negative side effects or have a weakened immune system, consult a medical professional.
To prevent mold growth on parmesan cheese, store it in an airtight container or wrap it tightly in plastic wrap. Ensure that the cheese is kept in a cool, dry place, such as a refrigerator.











































